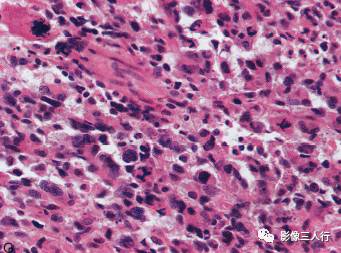
【病例】胶质母细胞瘤1例MR影像表现

【病例】胶质母细胞瘤1例MR影像表现
发布时间:2022-10-24
发布时间:2022-10-24
病史:
男性,57岁。剑突下疼痛半年,加重伴呕吐一周。实验室检查:WBC12.15×109。
左侧额颞叶多形性胶质母细胞瘤

A.T1WI横断面;B.T2WI横断面;CFLAIR横断面;D.T1WI增强;E.T1WI增强冠状面;F.T1WI增强矢状面;G.HE×40;H.GFAR( )×40
影像学表现:
左侧额颞叶见较大不规则囊实性肿块,大小约5.4cm×8.3cm,平扫T1WI呈低信号、T2WI呈高信号(图A、B),肿块内有斑片状囊变区;增强扫描肿块实性部分呈不均匀明显强化,囊性部分呈环形强化(图D~F)。肿块占位效应明显,周围见环形水肿(图C)。
手术所见:
左侧额颞部肿瘤组织松脆,质地不均,边界不清,血供一般,侵犯其表面的硬脑膜。病理结果:多形性胶质母细胞瘤(图G、H)。
分析与讨论:
胶质母细胞瘤又称多形性胶质母细胞瘤,具有高度恶性的生物学行为,可从良性的星形细胞瘤、少突胶质细胞瘤、室管膜瘤恶变而来,也可发生时即为胶质母细胞瘤。按WHO分类属IV级星形细胞瘤(9440/3),胶质母细胞瘤发病率占颅内肿瘤的8.78%,男性明显多于女性,约1.9:1。发病年龄分布较广,高峰年龄约31~40岁。好发于大脑半球,以额叶最为多见,其次为颞叶,再次为顶叶,范围广泛,常同时累及2~3个脑叶,或经胼胝体向对侧生长,呈蝴蝶状。临床表现以颅内压增高引起的头痛为主,可以伴有呕吐及视乳头水肿,依据肿瘤位置可以出现相应的症状和占位体征,如偏侧肢体无力、偏身感觉障碍等。MR表现:额叶肿瘤沿深部神经纤维越过胼胝体向对侧生长,呈蝴蝶状,也可以表现为彼此孤立的多发瘤灶,T1WI以不均匀的等、低信号为主,如合并囊变、出血,则呈高低混杂信号,T2WI为不均匀高、低混杂信号,瘤周可见大片水肿信号,增强扫描肿瘤实性部分明显强化,囊变、坏死及瘤周水肿区无强化。
两例肿瘤均为孤立病灶,瘤灶内有大片坏死,T1WI为低或稍低信号,T2WI肿块实性部分为等信号,坏死部分为高信号,周围可见大片水肿,边界欠清,增强扫描肿块实性部分不均匀强化,坏死囊变部分无强化,应注意与间变性室管膜瘤和原始神经外胚层瘤鉴别。
鉴别诊断:
①转移瘤:脑内转移瘤亦以中老年人多见,幕上多见,易发生出血、囊变和坏死。单发的转移瘤和胶质母细胞瘤表现相似。但转移瘤多位于皮髓交界区,且常有原发肿瘤的病史可资鉴别。②淋巴瘤:较少见,约占颅内肿瘤的1%左右。肿瘤多位于脑白质深部,T1WI多呈低或等信号,T2WI呈等或稍低信号;增强扫描多为“握拳样”或“团块样”强化,环形强化较少。③脑脓肿:在脓肿壁形成后,其边界清楚,平扫其壁表现为1层或2层T1WI等或稍高信号、T2WI低信号的较完整的环;增强后表现为薄壁、较规则的环形强化,与胶质母细胞瘤明显不同。